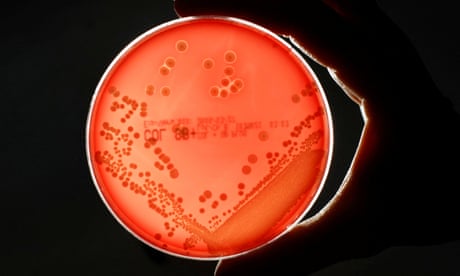

Protein found in Sydney rock oysters’ haemolymph can kill bacteria and boost some antibiotics’ effectiveness, scientists discover
An antimicrobial protein found in the blood of an Australian oyster could help in the fight against superbugs, new research suggests.
Australian scientists have discovered that a protein found in the haemolymph – the equivalent of blood – of the Sydney rock oyster, Saccostrea glomerata, can kill bacteria itself and increase the effectiveness of some conventional antibiotics.
Antimicrobial resistance has been described as a “looming global health crisis” that – without urgent action – could render critical drugs ineffective and result in declines in lifespan and life quality by 2050.
In lab tests, the haemolymph protein alone was effective at killing the bacteria Streptococcus pneumoniae, which mainly causes pneumonia, and Streptococcus pyogenes, the culprit for strep throat and scarlet fever. It has not yet been tested in animals or humans.
When used in combination with antibiotics, including ampicillin and gentamicin, it improved their effectiveness from two- to 32-fold against bacteria such as Staphylococcus aureus (golden staph) and Pseudomonas aeruginosa, which often infects immunocompromised people.
The study’s co-author Prof Kirsten Benkendorff, of Southern Cross University, estimated that about two dozen oysters would contain enough haemolymph to provide an active dose of the protein for an average person, but she emphasised that more research was needed to purify the protein and understand how it works.

“We found that heating [the protein] does actually reduce the antimicrobial activity, so cooking would reduce the effect,” Benkendorff said.
It is uncertain, however, whether eating the protein would be effective, as unlike many conventional antibiotics, antimicrobial proteins can be broken down by the digestive system before they reach their target site.
“I definitely would not suggest that people ate oysters instead of taking antibiotics if they have got a serious infection,” Benkendorff said.
She said “oysters as filter feeding organisms are sucking bacteria in through their bodies all the time”, making them good candidates in which to look for new antimicrobial drugs – but also means that in places such as near stormwater drains, they can accumulate substances that can be harmful to humans if consumed.
Benkendorff said the protein could help treat respiratory infections that are resistant to regular antibiotics because of biofilms.
To protect themselves, infectious bacteria often aggregate into biofilms – sticky communities that enable them to better evade antibiotics and the human immune system.
The oyster haemolymph protein was effective against Streptococcus biofilms, the scientists found.
“We often think about bacteria just floating around in the blood. But in reality, a lot of them actually adhere to surfaces,” Benkendorff said. “The advantage of having something that disrupts the biofilm is … it’s stopping all of those bacteria from attaching to the surfaces. It’s releasing them back out into the blood, where then they can be attacked by antibiotics.”
Prof Jonathan Iredell, an infectious diseases physician and clinical microbiologist at the University of Sydney, who was not involved in the research, said the oyster protein belonged to a class of compounds called antimicrobial peptides. “There is a lot of excitement about their discovery because they often contain interesting kinds of mechanisms that we haven’t seen before.”
The study, he said, added “to an exciting field where we’re looking to naturally occurring antimicrobials of a different type to try and provide new prospects in the face of advancing adaptation by bacteria”.
Prof Branwen Morgan, who leads the CSIRO’s minimising antimicrobial resistance mission, described the protein’s properties as a “really interesting discovery, given biofilms are so problematic”.
Morgan, who was not involved in the research, said any potential treatment that reduced the reliance on traditional antibiotics was worth pursuing, in light of the increase in drug-resistant infections around thee world.
“Given the significant costs in developing new medicines, the idea of using excess and/or imperfect oysters to generate a sustainable supply of antimicrobial proteins … should be investigated further,” she said.
The study was published in the journal Plos One.
News
New mRNA therapy targets drug-resistant pneumonia
Bacteria that multiply on surfaces are a major headache in health care when they gain a foothold on, for example, implants or in catheters. Researchers at Chalmers University of Technology in Sweden have found [...]
Current Heart Health Guidelines Are Failing To Catch a Deadly Genetic Killer
New research reveals that standard screening misses most people with a common inherited cholesterol disorder. A Mayo Clinic study reports that current genetic screening guidelines overlook most people who have familial hypercholesterolemia, an inherited disorder that [...]
Scientists Identify the Evolutionary “Purpose” of Consciousness
Summary: Researchers at Ruhr University Bochum explore why consciousness evolved and why different species developed it in distinct ways. By comparing humans with birds, they show that complex awareness may arise through different neural architectures yet [...]
Novel mRNA therapy curbs antibiotic-resistant infections in preclinical lung models
Researchers at the Icahn School of Medicine at Mount Sinai and collaborators have reported early success with a novel mRNA-based therapy designed to combat antibiotic-resistant bacteria. The findings, published in Nature Biotechnology, show that in [...]
New skin-permeable polymer delivers insulin without needles
A breakthrough zwitterionic polymer slips through the skin’s toughest barriers, carrying insulin deep into tissue and normalizing blood sugar, offering patients a painless alternative to daily injections. A recent study published in the journal Nature examines [...]
Multifunctional Nanogels: A Breakthrough in Antibacterial Strategies
Antibiotic resistance is a growing concern - from human health to crop survival. A new study successfully uses nanogels to target and almost entirely inhibit the bacteria P. Aeruginosa. Recently published in Angewandte Chemie, the study [...]
Nanoflowers rejuvenate old and damaged human cells by replacing their mitochondria
Biomedical researchers at Texas A&M University may have discovered a way to stop or even reverse the decline of cellular energy production—a finding that could have revolutionary effects across medicine. Dr. Akhilesh K. Gaharwar [...]
The Stunning New Push to Protect the Invisible 99% of Life
Scientists worldwide have joined forces to build the first-ever roadmap for conserving Earth’s vast invisible majority—microbes. Their new IUCN Specialist Group reframes conservation by elevating microbial life to the same urgency as plants and [...]
Scientists Find a Way to Help the Brain Clear Alzheimer’s Plaques Naturally
Scientists have discovered that the brain may have a built-in way to fight Alzheimer’s. By activating a protein called Sox9, researchers were able to switch on star-shaped brain cells known as astrocytes and turn them into [...]
Vision can be rebooted in adults with amblyopia, study suggests
Temporarily anesthetizing the retina briefly reverts the activity of the visual system to that observed in early development and enables growth of responses to the amblyopic eye, new research shows. In the common vision [...]
Ultrasound-activated Nanoparticles Kill Liver Cancer and Activate Immune System
A new ultrasound-guided nanotherapy wipes out liver tumors while training the immune system to keep them from coming back. The study, published in Nano Today, introduces a biodegradable nanoparticle system that combines sonodynamic therapy and cell [...]
Magnetic nanoparticles that successfully navigate complex blood vessels may be ready for clinical trials
Every year, 12 million people worldwide suffer a stroke; many die or are permanently impaired. Currently, drugs are administered to dissolve the thrombus that blocks the blood vessel. These drugs spread throughout the entire [...]
Reviving Exhausted T Cells Sparks Powerful Cancer Tumor Elimination
Scientists have discovered how tumors secretly drain the energy from T cells—the immune system’s main cancer fighters—and how blocking that process can bring them back to life. The team found that cancer cells use [...]
Very low LDL-cholesterol correlates to fewer heart problems after stroke
Brigham and Women's Hospital's TIMI Study Group reports that in patients with prior ischemic stroke, very low achieved LDL-cholesterol correlated with fewer major adverse cardiovascular events and fewer recurrent strokes, without an apparent increase [...]
“Great Unified Microscope” Reveals Hidden Micro and Nano Worlds Inside Living Cells
University of Tokyo researchers have created a powerful new microscope that captures both forward- and back-scattered light at once, letting scientists see everything from large cell structures to tiny nanoscale particles in a single shot. Researchers [...]
Breakthrough Alzheimer’s Drug Has a Hidden Problem
Researchers in Japan found that although the Alzheimer’s drug lecanemab successfully removes amyloid plaques from the brain, it does not restore the brain’s waste-clearing system within the first few months of treatment. The study suggests that [...]















